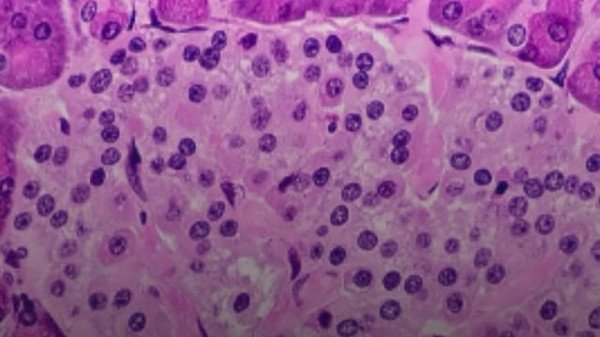

Condição silenciosa ligada à obesidade e diabetes tipo 2 pode se desenvolver por anos sem sintomas evidentes.
A resistência à insulina, ligada a obesidade e diabetes tipo 2, pode se desenvolver silenciosamente por anos. Sintomas incluem fadiga e aumento abdominal.
A resistência à insulina tem se tornado um dos maiores desafios de saúde, estando ligada ao aumento dos casos de obesidade, diabetes tipo 2 e doenças cardiovasculares. A condição é silenciosa e pode se desenvolver ao longo de anos, mesmo sem sintomas evidentes, até que os níveis de glicose no sangue comecem a sair do controle.
O maior problema surge quando o corpo para de responder de forma adequada ao hormônio insulina, responsável por levar a glicose para dentro das células. Como resposta, o pâncreas tenta compensar produzindo mais insulina, até que não consegue mais sustentar o ritmo, e o açúcar passa a se acumular na corrente sanguínea.
A resistência à insulina costuma surgir quando o equilíbrio metabólico do corpo é rompido por fatores ligados ao estilo de vida. Alimentação rica em açúcares, excesso de gordura abdominal, sono irregular e estresse constante criam um ambiente inflamatório que dificulta a ação da insulina nas células.
Com o tempo, esse processo altera o funcionamento do pâncreas e abre caminho para o desenvolvimento da diabetes tipo 2. Condições hormonais, como síndrome dos ovários policísticos e menopausa, assim como o uso prolongado de corticoides, também elevam o risco da resistência à insulina.
Sintomas Iniciais
Nos estágios iniciais, a resistência à insulina costuma se desenvolver de forma silenciosa. Mesmo assim, o corpo dá alguns sinais de que algo está fora do equilíbrio.
Entre os principais sintomas, destacam-se: aumento da circunferência abdominal, dificuldade para perder peso, fadiga e sensação de cansaço constante, sonolência logo após as refeições, vontade frequente de comer doces e alterações nos níveis de colesterol e triglicerídeos.